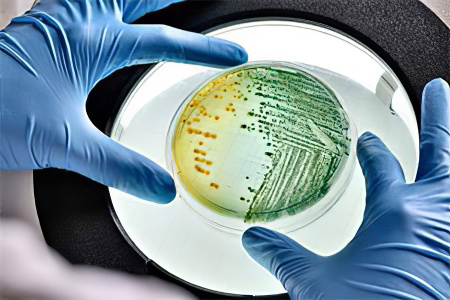

Зачем сдавать анализ кала на дисбактериоз?
В нашем организме обитает триллионы бактерий, которые находятся в симбиотических отношениях с нами. Это значит, что они получают выгоду от нашего тела, а мы — от них. Однако не все микроорганизмы одинаково полезны: некоторые желательны, другие менее приемлемы, а некоторые могут быть опасными. Анализ кала на дисбактериоз помогает определить количественное соотношение различных колоний бактерий в кишечнике.
Врачи подчеркивают, что анализ кала на дисбактериоз является важным инструментом для оценки состояния микрофлоры кишечника. Результаты этого анализа помогают выявить дисбаланс между полезными и патогенными бактериями, что может быть причиной различных заболеваний. Специалисты отмечают, что расшифровка результатов требует внимательного подхода, так как на показатели могут влиять множество факторов, включая диету, прием антибиотиков и общее состояние здоровья пациента.
Врачи рекомендуют не только полагаться на результаты анализа, но и учитывать клинические проявления, такие как нарушения пищеварения, боли в животе или изменения стула. Важно помнить, что нормальные показатели могут варьироваться в зависимости от лаборатории, поэтому консультация с врачом необходима для правильной интерпретации данных. В конечном итоге, анализ кала на дисбактериоз служит отправной точкой для дальнейшего обследования и выбора оптимальной стратегии лечения.

Показания для назначения исследования:
- Диарея или запор;
- Тошнота и рвота;
- Метеоризм;
- Чувство тяжести, дискомфорт, вздутие, боли в животе;
- Подозрение на кишечную инфекцию;
- Резкое снижение веса без видимых причин;
- Непереносимость определенных продуктов;
- Аллергические реакции, кожные высыпания;
- Наличие патологических примесей в кале (слизь, кровь, гной).
Рекомендуется пройти анализ кала на дисбактериоз после длительного лечения антибактериальными или гормональными препаратами. Результаты помогут понять, как лечение повлияло на состав кишечной микрофлоры и нужно ли её корректировать.
| Бактерия/Группа бактерий | Нормальное количество (приблизительно) | Возможные отклонения и их значение |
|---|---|---|
| Бифидобактерии | 107-109 КОЕ/г | Снижение: дисбиоз, снижение иммунитета, нарушение пищеварения. Повышение: может быть вариантом нормы, но иногда указывает на компенсаторные процессы. |
| Лактобактерии | 106-108 КОЕ/г | Снижение: дисбиоз, снижение иммунитета, нарушение пищеварения. Повышение: может быть вариантом нормы. |
| Энтерококки | 105-107 КОЕ/г | Повышение: может указывать на дисбиоз, воспалительные процессы в кишечнике. |
| Кишечная палочка | 107-108 КОЕ/г | Снижение: дисбиоз. Повышение: может указывать на дисбиоз, воспалительные процессы. |
| Клостридии | <105 КОЕ/г | Повышение: указывает на дисбиоз, возможно, на гниение в кишечнике. |
| Грибы рода Candida | Отсутствуют или <104 КОЕ/г | Повышение: кандидоз, дисбиоз, снижение иммунитета. |
| Стафилококки | Отсутствуют или <104 КОЕ/г | Повышение: указывает на дисбиоз, возможно, на воспалительные процессы. |
| Протей | Отсутствуют | Наличие: указывает на дисбиоз, гнилостные процессы. |
Методы диагностики:
-
Копроскопия — это «общий анализ кала», который является первым шагом в диагностике кишечных нарушений. Результатом исследования является копрограмма, содержащая данные о цвете, форме, консистенции и запахе кала, а также информацию о наличии скрытой крови, гноя, слизи, паразитов и их яиц, непереваренных остатках пищи, атипичных клетках и фрагментах тканей. Если результаты вызывают опасения, врач может назначить дополнительные исследования.
-
Бактериологический анализ кала — это посев материала на питательную среду. Через 4-5 дней бактерии размножаются, и лаборант может определить количество основных представителей кишечной микрофлоры в 1 грамме образца (КОЕ/г). Этот метод прост и доступен, выполняется в любой больнице и остается основным способом диагностики дисбактериоза у детей и взрослых. Однако он требует строгого соблюдения правил подготовки и сбора материала и занимает много времени, что привело к разработке альтернативного метода.
-
Биохимический анализ кала — это современная процедура, основанная на газожидкостной хроматографии жирных кислот. Результаты можно получить всего через несколько часов, и они отражают баланс пристеночной микрофлоры кишечника. Этот анализ более чувствителен и точен, для него подойдет даже образец, собранный накануне, так как жирные кислоты, выделяемые бактериями, долго сохраняются в неизменном виде. Метод позволяет определить, в каком отделе кишечника произошел сбой. Единственный недостаток — не все лаборатории имеют необходимое оборудование.
Анализ кала на дисбактериоз — это важный инструмент для оценки состояния микрофлоры кишечника. Многие пациенты отмечают, что расшифровка результатов может вызывать недоумение. Часто встречаются термины, которые не всегда понятны, и это приводит к множеству вопросов. Люди делятся своими впечатлениями о том, как важно правильно интерпретировать данные, чтобы понять, есть ли нарушения в балансе бактерий. Некоторые отмечают, что результаты могут варьироваться в зависимости от времени суток, питания и даже стресса. Поэтому важно не только получить анализ, но и проконсультироваться с врачом, который поможет расшифровать результаты и предложит адекватное лечение. В конечном итоге, многие приходят к выводу, что анализ кала — это первый шаг к восстановлению здоровья и нормализации пищеварения.

Нормы биохимического анализа кала:
| Показатель | Абсолютное значение (мг/г) | Относительное значение (ед.) |
| Уксусная кислота (C2) | 5,35-6,41 | 0,612-0,656 |
| Пропионовая кислота (C3) | 1,63-1,95 | 0,180-0,198 |
| Масляная кислота (C4) | 1,60-1,90 | 0,167-0,185 |
| ИзоСn/Cn | 0,29-0,57 | 0,30-0,60 |
| Общее содержание кислот | 8,01-13,01 | 9,00-12,01 |
| Анаэробный индекс | от -0,686 до -0,466 | от -0,576 до -0,578 |
Подготовка к исследованию и сбор материала
Правильная подготовка и своевременная доставка образца кала для анализа на дисбактериоз имеют огромное значение. Рассмотрим основные моменты, которые следует учесть.
- Если вы недавно проходили курс антибиотиков, сдавать анализ рекомендуется не ранее чем через две недели после завершения лечения.
- За три дня до анализа исключите использование слабительных, противодиарейных и антигельминтных препаратов, нестероидных противовоспалительных средств, пробиотиков и пребиотиков, касторового и вазелинового масла, а также препаратов бария и висмута.
- Заранее приобретите в аптеке или получите в лаборатории стерильный пластиковый контейнер с ложечкой и герметичной крышкой для сбора и транспортировки кала.
- Дефекация должна происходить естественным образом, без применения клизм или других вспомогательных средств.
- Образец нельзя собирать из унитаза. Подготовьте любую удобную емкость, тщательно вымойте её, обдайте кипятком и обсушите, затем используйте для дефекации.
- Перед сбором образца обязательно опорожните мочевой пузырь, подмойтесь и вытеритесь. В образец не должны попасть моча или выделения из половых органов. Если у женщины менструация, рекомендуется использовать тампон.
- После дефекации откройте подготовленный контейнер, возьмите ложечку и наберите небольшое количество материала из разных участков каловых масс: из середины и с поверхности. Если вы заметили подозрительный участок с слизью или кровью, отличающийся по консистенции или цвету, обязательно поместите его в контейнер! Для анализа потребуется 6-8 ложечек кала.
- Плотно закройте контейнер и доставьте образец в лабораторию в течение двух часов после сбора.
Большинство бактерий, составляющих кишечную микрофлору, являются анаэробными и под воздействием воздуха начинают погибать. Поэтому так важно вовремя сдать анализ кала на дисбактериоз — это обеспечит достоверность результатов.
Если вы проходите биохимическое исследование, срочность не так критична: образец можно заморозить и доставить в лабораторию на следующий день. Это особенно удобно для родителей маленьких детей, так как не всегда удается собрать кал у ребенка рано утром, когда он может просто не захотеть в туалет.

Анализ кала на дисбактериоз у грудничка
Нормы бактериологического анализа кала у новорождённых, младенцев и детей старшего возраста отличаются от аналогичных показателей у взрослых. Эти различия становятся более заметными с уменьшением возраста ребёнка, что связано с постепенным заселением его организма микрофлорой. Процесс колонизации может проходить по-разному у детей на грудном и искусственном вскармливании. Мы подробнее рассмотрим это при интерпретации результатов анализа кала на дисбактериоз в таблице.
Кишечная микрофлора грудничков может подвергаться негативным изменениям из-за инфекций, полученных в больнице, таких как золотистый стафилококк, синегнойная палочка и дрожжеподобные грибы. В лучшем случае это вызывает временные и незначительные проблемы со здоровьем, в худшем – приводит к серьёзным заболеваниям. Поэтому родителям следует внимательно следить за состоянием малыша, его поведением, состоянием кожи и слизистых оболочек, а также частотой и качеством стула, особенно после стационарного лечения.
Анализ кала на дисбактериоз грудному ребёнку рекомендуется сдавать при наличии следующих симптомов:
- Частая и сильная отрыжка после кормления, напоминающая рвоту;
- Вздутие живота, колики, метеоризм;
- Снижение аппетита;
- Проблемы с введением прикорма;
- Симптомы непереносимости определённых продуктов;
- Высыпания или пятна на коже и/или слизистых оболочках;
- Недавний курс антибактериальной или гормональной терапии;
- Любые нарушения стула – изменения частоты, аномальный внешний вид или запах каловых масс, наличие патологических примесей (кровь, слизь, гной).
Чтобы результаты исследования были максимально точными, необходимо правильно подготовиться к анализу:
- Не вводите новый прикорм как минимум за 3-4 дня до посещения лаборатории;
- Накануне не давайте ребёнку овощи или фрукты, которые могут изменить цвет стула (например, морковное пюре, красные и чёрные ягоды, свекольный сок и т.д.);
- Завершите приём любых медикаментов за несколько дней до сдачи анализа, включая слабительные и витамины. Антибактериальную терапию желательно закончить за 2 недели до исследования. Обо всех принимаемых препаратах лучше сообщить врачу и проконсультироваться о сроках проведения анализа кала на дисбактериоз;
- Приобретите стерильный пластиковый контейнер с ложечкой. Образец детских испражнений можно взять с поверхности подгузника, но только если наполнитель не гелевый. Лучше использовать чистую хлопчатобумажную пелёнку, предварительно прогладив её горячим утюгом. Для анализа достаточно собрать 2 ложечки материала.
Таблица норм бактериологического анализа кала
| Тип микрофлоры | Показатели | Грудные дети | Дети старше 1 года | Взрослые |
| Полезные микроорганизмы | Бифидобактерии | 10^10 – 10^11 | 10^9 – 10^10 | 10^8 – 10^10 |
| Лактобактерии | 10^6 – 10^7 | 10^7 – 10^8 | 10^6 – 10^8 | |
| Условно-патогенные микроорганизмы | Пептострептококки | 10^3 – 10^5 | 10^5 – 10^6 | 10^5 – 10^6 |
| Эшерихия (типичная) | 10^6 – 10^7 | 10^7 – 10^8 | 10^6 – 10^8 | |
| Эшерихия (лактозонегативная) | ≤10^5 | ≤10^5 | ≤10^5 | |
| Фузобактерии | ≤10^6 | 10^8 – 10^9 | 10^8 – 10^9 | |
| Бактероиды | 10^7 – 10^8 | 10^9 – 10^10 | 10^9 – 10^10 | |
| Эубактерии | 10^6 – 10^7 | 10^9 – 10^10 | 10^9 – 10^10 | |
| Энтерококки | 10^5 – 10^7 | 10^5 – 10^8 | 10^5 – 10^8 | |
| Стафилококки (сапрофитный и эпидермальный) | ≤10^4 | ≤10^4 | ≤10^4 | |
| Вейлонеллы | ≤10^5 | 10^5 – 10^6 | 10^5 – 10^6 | |
| Клостридии | ≤10^3 | ≤10^5 | ≤10^5 | |
| Кандиды | ≤10^3 | ≤10^4 | ≤10^4 | |
| Другие условно-патогенные бактерии | ≤10^4 | ≤10^4 | ≤10^4 | |
| Патогенные микроорганизмы | Сальмонеллы | отрицательные (отсутствуют) | отрицательные (отсутствуют) | отрицательные (отсутствуют) |
| Шигеллы | отрицательные (отсутствуют) | отрицательные (отсутствуют) | отрицательные (отсутствуют) | |
| Иерсинии | отрицательные (отсутствуют) | отрицательные (отсутствуют) | отрицательные (отсутствуют) | |
| Синегнойная палочка | отрицательные (отсутствуют) | отрицательные (отсутствуют) | отрицательные (отсутствуют) | |
| Эшерихия (гемолитическая) | отрицательные (отсутствуют) | отрицательные (отсутствуют) | отрицательные (отсутствуют) | |
| Стафилококк (золотистый) | отрицательные (отсутствуют) | отрицательные (отсутствуют) | отрицательные (отсутствуют) |
Расшифровка результатов исследования
Кишечную микрофлору можно условно разделить на три категории:
- Полезные бактерии — эти микроорганизмы оказывают положительное влияние на функционирование организма, поэтому их количество должно быть достаточным. К ним относятся бифидобактерии и лактобациллы.
- Условно-патогенные бактерии — некоторые из них могут быть полезными, если находятся в гармонии с другими компонентами микрофлоры. Однако при превышении их численности и уменьшении антагонистов они могут стать вредными, особенно при ослаблении иммунной системы. Примеры таких бактерий: кандида, энтерококки и клостридии.
- Патогенные бактерии — в организме здорового человека они не должны присутствовать. Эти микроорганизмы не приносят пользы и могут вызывать серьезные проблемы. Если иммунная система не справится с их атакой, это может привести к опасным заболеваниям. К таким бактериям относятся золотистый стафилококк, сальмонелла, шигелла и другие «нежелательные гости» кишечника.
Теперь давайте подробнее рассмотрим ключевых представителей кишечной микрофлоры. В результатах анализа кала на дисбактериоз некоторые из перечисленных бактерий могут отсутствовать, так как в разных лабораториях действуют различные стандарты, особенно в частных учреждениях. Поэтому лучше всего доверить интерпретацию результатов квалифицированному врачу, а мы лишь предоставляем общепринятые нормы и указываем на возможные причины отклонений.
Бифидобактерии
Название этого микроорганизма происходит от латинских слов «бактерия» и «бифидус», что переводится как «разделенный пополам». Бифидобактерия имеет форму изогнутой палочки длиной от 2 до 5 мкм с раздвоенными концами. Она относится к классу грамположительных анаэробов. Микрофлора кишечника здорового человека на 95% состоит из бифидобактерий. Нормальные показатели для младенцев до года составляют 10 в десятой или одиннадцатой степени КОЕ/г, а для детей старшего возраста и взрослых — 10 в девятой или десятой степени КОЕ/г.
Недостаток этих полезных бактерий является главной причиной обращения к врачу с жалобами на кишечные проблемы. Анализ кала на дисбактериоз почти всегда показывает снижение их количества. При нехватке бифидобактерий нарушается усвоение витаминов и микроэлементов, ухудшается углеводный обмен, снижается местный иммунитет и увеличивается токсическая нагрузка на печень и почки. Восстановить микрофлору кишечника и восполнить дефицит бифидобактерий довольно просто — для этого существует множество специализированных препаратов.
Бифидобактерии в кале снижены — причины:
- Длительное применение антибиотиков, гормонов, нестероидных противовоспалительных средств, слабительных и противоглистных препаратов;
- Неправильное питание — избыток углеводов или жиров в рационе, голодание, строгие монодиеты;
- Искусственное вскармливание грудных детей, слишком раннее введение прикорма;
- Врожденные ферментопатии — непереносимость лактозы, фруктозы, глютена и других пищевых компонентов;
- Иммунодефицитные состояния, аллергические реакции;
- Кишечные инфекции — дизентерия, сальмонеллез, иерсиниоз;
- Паразитарные инвазии — аскаридоз, энтеробиоз, лямблиоз;
- Хронические заболевания желудочно-кишечного тракта — энтероколит, холецистит, гастрит, панкреатит, язва желудка;
- Эмоциональный стресс;
- Резкая смена климата.
Лактобактерии
Название этих полезных представителей кишечной микрофлоры происходит от латинского слова «лак», что переводится как «молоко». Существует множество видов лактобацилл, которые обитают не только в кишечнике, но и в других органах, например, в женских половых. Лактобациллы — это грамположительные факультативно-анаэробные микроорганизмы в форме тонких палочек, составляющие около 3% от общего числа бактерий в кишечнике. Согласно анализу кала на дисбактериоз, нормальное содержание лактобацилл у грудных детей составляет 10^6 или 10^7 КОЕ/г, а у взрослых — 10^7 или 10^8 КОЕ/г.
Лактобактерии производят органические кислоты, что помогает поддерживать оптимальный уровень pH в кишечнике. Они играют важную роль в пищеварении, расщепляя молочный сахар и предотвращая лактазную недостаточность. Без достаточного количества лактобацилл нормальное усвоение молока невозможно. Эти микроорганизмы необходимы для стимуляции местного иммунитета, так как, будучи чуждыми элементами, они активизируют работу иммунокомпетентных клеток в пристеночной зоне кишечника. Лактобактерии также участвуют в метаболизме желчных кислот, способствуют нормальной перистальтике и предотвращают затвердевание каловых масс, что снижает риск запоров.
Причины снижения лактобактерий в кале:
- Длительное применение антибиотиков без поддержки пре- и пробиотиков, бесконтрольный прием НПВС (аспирина, анальгина, ибупрофена), использование слабительных или противогельминтных средств;
- Неправильное питание, голодание, монодиеты;
- Искусственное вскармливание или слишком раннее введение прикорма у младенцев;
- Острые кишечные инфекции;
- Хронические заболевания желудочно-кишечного тракта;
- Сильный стресс.
Пептострептококки
Эти микроорганизмы относятся к условно-патогенной флоре и представляют собой небольшие округлые клетки, образующие короткие цепочки и передвигающиеся с помощью ресничек. Пептострептококки — грамположительные анаэробные бактерии, не образующие споры. Они обитают в ротовой полости, влагалище, кишечнике и на коже, составляя до 18% всех грамположительных анаэробных кокков в человеческом организме. Согласно анализу кала на дисбактериоз, нормальное содержание пептострептококков у детей до одного года не должно превышать 10^5 КОЕ/г, а у взрослых — 10^6 КОЕ/г.
Пептострептококки играют незначительную роль в обмене белков и углеводов, а также производят водород, необходимый для поддержания здорового кислотно-щелочного баланса в кишечнике. Однако их количество должно контролироваться иммунной системой и другими представителями микрофлоры. Избыточное размножение пептострептококков может привести к смешанным абдоминальным инфекциям с участием других условно-патогенных и патогенных бактерий. Например, в 20% случаев перитонита обнаруживаются пептострептококки. Они также могут быть выявлены при гинекологических воспалительных заболеваниях и гнойных абсцессах в полости рта.
Причины повышения пептострептококков в кале:
- Острая кишечная инфекция;
- Хронические заболевания желудочно-кишечного тракта;
- Избыточное потребление сахаров в рационе.
Эшерихия типичная
Кишечная палочка (Escherichia coli, эшерихия типичная) — грамотрицательная факультативно-анаэробная бактерия, не образующая спор. Большинство её штаммов условно-патогенны и являются естественными обитателями микрофлоры кишечника. Уже в первые сорок часов после рождения кишечник новорожденного начинает заселяться эшерихиями. Согласно анализу кала на дисбактериоз, нормальные показатели E. coli у грудных детей составляют 10^6 или 10^7 КОЕ/г, тогда как у детей старшего возраста и взрослых — 10^7 или 10^8 КОЕ/г. В сравнении с другими микроорганизмами кишечная палочка составляет около 1% от общего количества бактерий в кишечнике.
Типичная эшерихия приносит пользу организму человека: она участвует в синтезе витаминов группы B и K, а также в метаболизме холестерина, билирубина и холина. Она содействует усвоению железа и кальция, производит необходимые кислоты (уксусную, молочную, янтарную, муравьиную) и колицины, уничтожающие патогенные бактерии. Кроме того, кишечная палочка поглощает избыток кислорода, который может быть вреден для лактобацилл и бифидобактерий. Поэтому, несмотря на условно-патогенный характер E. coli, её недостаток в организме крайне нежелателен.
Причины пониженного уровня эшерихий в кале:
- Длительное применение антибиотиков;
- Острая кишечная инфекция;
- Паразитарные инфекции;
- Неправильное питание;
- Искусственное вскармливание новорожденных.
Эшерихия лактозонегативная
Наличие лактозонегативной кишечной палочки в анализах кала на дисбактериоз считается нормальным. Уровень этой палочки у детей и взрослых не должен превышать 10^5 КОЕ/г.
Если показатель превышает норму, это может быть тревожным сигналом, особенно при дефиците полноценной эшерихии. Лактозонегативный штамм не выполняет функции E. coli и занимает место без пользы. При ослаблении иммунной системы такая кишечная палочка может поддерживать вредные бактерии и усугублять воспалительные процессы. У маленьких детей повышенное содержание лактозонегативной эшерихии в кале может косвенно указывать на глистную инвазию, поэтому такие результаты требуют дополнительного обследования.
Фузобактерии
Фузобактерии — это грамотрицательные анаэробные микроорганизмы с полиморфной формой. Они не имеют органоидов для движения, не образуют споры и капсулы. Внешне эти бактерии представляют собой тонкие палочки длиной от 2 до 3 мкм с заостренными концами. Фузобактерии являются естественными обитателями микрофлоры ротовой полости, верхних дыхательных путей, желудочно-кишечного тракта и половых органов. Согласно нормам анализа кала на дисбактериоз, в кишечнике грудных детей допустимо содержание фузобактерий до 10^6 КОЕ/г, а у взрослых — до 10^8 КОЕ/г.
Фузобактерии считаются условно-патогенными. Хотя они не выполняют полезных функций в организме человека, могут участвовать в конкурентной борьбе с более опасными микроорганизмами. При ослабленном иммунитете некоторые виды фузобактерий способны вызывать гнойно-септические воспаления. У детей с ослабленным иммунитетом и пожилых людей при тяжелой ангине может развиться серьезное осложнение — фузоспирохетоз, представляющее собой некротический процесс, поражающий слизистые оболочки ротовой полости и горла.
Бактероиды
Это условно-патогенные грамотрицательные анаэробные бактерии с палочковидной формой. Они занимают второе место по численности в кишечной микрофлоре, уступая лишь бифидобактериям. Нормы для бактероидов в анализе кала на дисбактериоз следующие: у детей до одного года — 10 в седьмой или восьмой степени КОЕ/г, у взрослых — 10 в девятой или десятой степени КОЕ/г. У детей до 6-8 месяцев бактероиды обычно не обнаруживаются, особенно при грудном вскармливании без прикорма.
В нормальных концентрациях бактероиды полезны, так как участвуют в метаболизме жиров. Однако при чрезмерном размножении они начинают конкурировать с кишечной палочкой за кислород, что может привести к нарушениям пищеварения, нехватке витаминов и микроэлементов, снижению местного иммунитета и другим проблемам. Рост популяции бактероидов сдерживают их естественные антагонисты — лактобациллы и бифидобактерии. Если анализ кала показывает повышенное содержание бактероидов, рекомендуется пройти курс препаратов для восстановления здоровой микрофлоры.
Бактероиды в кале повышены – возможные причины:
- Избыточное потребление жиров;
- Недостаток бифидо- и лактобактерий.
Бактероиды в кале снижены – возможные причины:
- Длительное применение антибиотиков;
- Острая кишечная инфекция;
- Паразитарная инвазия.
Эубактерии
Грамположительные анаэробные бактерии имеют форму коротких толстых столбиков или сплющенных сфер. Они обладают прочными клеточными стенками и не образуют спор. Эубактерии являются частью естественной микрофлоры кишечника, но относятся к условно-патогенным микроорганизмам. Некоторые их штаммы могут вызывать воспалительные процессы в ротовой полости, дыхательных путях, половых органах, суставах, сердце и головном мозге, а также способствовать возникновению послеоперационных осложнений. Нормальные показатели содержания эубактерий в кишечнике, согласно анализу кала на дисбактериоз, составляют: для новорожденных — 10^6 или 10^7 КОЕ/г, для детей старшего возраста, взрослых и пожилых людей — 10^9 или 10^10 КОЕ/г.
Эти данные показывают, что эубактерии являются значительным компонентом кишечной микрофлоры. Интересно, что у грудных детей на грудном вскармливании эти бактерии встречаются крайне редко, тогда как у детей на искусственном вскармливании они присутствуют почти всегда. Эубактерии в оптимальных количествах полезны для организма: они участвуют в обмене холестерина и гормонов, синтезируют важные органические кислоты, ферментируют углеводы, вырабатывают витамины и расщепляют целлюлозу. Однако их избыток, особенно при снижении иммунной защиты, может представлять угрозу для здоровья.
Увеличение уровня эубактерий в кале является специфическим индикатором наличия полипов в толстом кишечнике, что требует дополнительного обследования (ректороманоскопия, колоноскопия).
Энтерококки
Грамположительные факультативно-анаэробные кокки, образующие пары или цепочки, не способны к образованию спор. Энтерококки являются частью условно-патогенной микрофлоры и встречаются в кишечнике людей всех возрастов, составляя до 25% от общего числа кокковых форм в этом органе. Нормальные значения содержания энтерококков в анализе кала на дисбактериоз следующие: у новорожденных — от 10^5 до 10^7 КОЕ/г, у детей старшего возраста и взрослых — от 10^5 до 10^8 КОЕ/г.
Энтерококки выполняют полезные функции, включая участие в углеводном обмене, синтез витаминов и поддержание местного иммунитета. Однако их численность не должна превышать количество кишечной палочки, иначе это может привести к её гибели в результате конкурентной борьбы. В последнее время мнение специалистов о безвредности энтерококков становится всё более сомнительным. Появились мутировавшие штаммы, устойчивые к мощным антибиотикам, таким как бета-лактамные пенициллины, цефалоспорины, аминогликозиды и даже ванкомицин. Зафиксированы случаи внутрибольничных инфекций, послеоперационных осложнений и воспалительных заболеваний, вызванных энтерококками, включая менингит и эндокардит.
Причины повышения энтерококков в кале:
- Аутоиммунные заболевания;
- Состояния иммунодефицита;
- Аллергические реакции;
- Паразитарные инфекции;
- Неправильное питание;
- Длительное применение антибиотиков;
- Недостаток кишечной палочки.
Стафилококк сапрофитный и эпидермальный
Грамположительные факультативно-анаэробные кокки размером до 1,2 мкм, не образующие споры и неподвижные, образуют группы, напоминающие виноградные гроздья. Сапрофитный стафилококк в основном встречается в мочеполовом тракте, а эпидермальный — на поверхности кожи и слизистых оболочек. Оба типа относятся к условно-патогенной микрофлоре и могут присутствовать в норме в анализах кала на дисбактериоз: до 10 в четвертой степени КОЕ/г у детей и взрослых.
Пока иммунная система контролирует эти стафилококки, они не причиняют значительного вреда здоровью. Однако и пользы от них нет. Размножение сапрофитного стафилококка в кишечнике может привести к острым воспалительным заболеваниям, таким как цистит или уретрит, особенно при неправильной гигиене после туалета. Эпидермальный стафилококк может вызвать конъюнктивит, если тереть глаза грязными руками. Увеличение уровня этих видов стафилококка в кале является тревожным сигналом, и при значительном превышении может потребоваться антибактериальная терапия.
Вейлонеллы
Грамотрицательные анаэробные кокки — это мелкие неподвижные микроорганизмы, не образующие спор и обычно формирующие неправильные скопления. Вейлонеллы считаются условно-патогенными бактериями, которые могут сосуществовать с человеком без вреда. Однако некоторые их штаммы способны вызывать гнойно-септические воспалительные процессы. При интерпретации результатов анализа кала на дисбактериоз применяются следующие нормы: для детей до года — не более 10 в пятой степени КОЕ/г, для детей старшего возраста и взрослых — 10 в пятой или шестой степени КОЕ/г. Интересно, что при естественном вскармливании вейлонеллы обнаруживаются менее чем у половины грудных детей.
Эти бактерии играют важную роль, расщепляя молочную кислоту. Исследования показывают возможную связь между недостатком вейлонелл и повышенным риском развития астмы у детей. Однако некоторые виды этих микроорганизмов обладают выраженными парадонтогенными свойствами: они накапливаются в зубных бляшках, вызывая воспаление десен и потерю зубов. Например, Veillonella parvula может вызывать колит у человека. Кроме того, даже полезные штаммы вейлонелл при избытке в кишечнике могут привести к повышенному газообразованию, диспепсии и диарее.
Клостридии
Грамположительные облигатно-анаэробные палочковидные бактерии, способные образовывать эндоспоры, называются клостридиями. Название происходит от греческого слова «веретено», поскольку спора, расположенная в центре клетки, обычно больше по диаметру, чем сама клетка, из-за чего она раздувается и напоминает веретено. Род клостридий разнообразен: среди них есть как условно-патогенные виды, так и возбудители серьезных заболеваний, таких как столбняк, ботулизм и газовая гангрена. Нормальные показатели содержания клостридий в кале при анализе на дисбактериоз составляют: у младенцев — не более 10^3 КОЕ/г, у взрослых — не более 10^4 КОЕ/г.
Клостридии играют важную роль в организме, участвуя в белковом обмене. В процессе их метаболизма образуются токсичные вещества индол и скатол. В небольших количествах они способствуют улучшению перистальтики, помогая продвижению каловых масс и предотвращая запоры. Однако, если количество клостридий в кишечнике становится чрезмерным, это может привести к гнилостной диспепсии, проявляющейся водянистыми поносами с неприятным запахом, тошнотой, вздутием, метеоризмом, коликами и иногда повышением температуры. При ослабленном иммунитете и в сочетании с другими патогенными бактериями клостридии могут вызывать воспалительные заболевания, такие как некротический энтероколит, цистит, уретрит, вагинит, простатит и другие.
Кандиды
Дрожжеподобные грибы класса дейтеромицетов — это одноклеточные микроорганизмы округлой или овальной формы, образующие псевдомицелий, состоящий из длинных тонких нитей. Наиболее известные представители этого класса — Candida albicans и Candida tropicalis. Эти грибы присутствуют в организме человека с первых месяцев жизни, обитая на слизистых оболочках ротовой полости, половых органов и в кишечнике. Кандиды считаются условно-патогенной флорой. При анализе кала на дисбактериоз их количество не должно превышать 10 в четвёртой степени КОЕ/г для людей любого возраста.
Кандиды играют важную роль в поддержании уровня pH, и в нормальном количестве они полезны для организма. Однако при превышении нормы может развиться местный или системный кандидоз. Грибки способны вызывать инфекции в ротовой полости (кандидозный стоматит), прямой кишке (кандидозный проктит), влагалище (так называемая «молочница») и других областях. Эти заболевания крайне неприятны, сопровождаются зудом, болью и выделениями, а также сложно поддаются лечению, поскольку дрожжеподобные грибы являются одними из самых устойчивых и быстро размножающихся микроорганизмов.
Повышенное содержание кандид в кале может быть вызвано следующими факторами:
- Чрезмерное потребление углеводов и сладостей;
- Длительное применение антибиотиков без поддержки противогрибковыми средствами;
- Использование гормональных контрацептивов;
- Беременность;
- Сахарный диабет;
- Эмоциональный стресс;
- Изменение климатических условий.
Другие условно-патогенные бактерии
В результате бактериологического анализа кала в питательной среде могут быть выявлены условно-патогенные микроорганизмы, такие как клебсиеллы, хафнии, серрации, протеи, энтеробактеры, цитробактеры и морганеллы. Все они относятся к лактозонегативным бактериям и могут представлять угрозу для здоровья. В норме их общее количество в кишечнике не должно превышать 10^4 КОЕ/г. Если результаты анализа показывают превышение этого значения, бактерия, вызвавшая отклонение, фиксируется в бланке с результатами как дополнительный показатель. Существенный рост условно-патогенной флоры (10^6 КОЕ/г и выше) требует дальнейшего обследования и лечения.
Наиболее опасные представители этой группы бактерий:
- Клебсиеллы – антагонисты лактобактерий, способствующие возникновению аллергии, запоров и лактазной недостаточности. Они проявляют себя изменением цвета и кислым запахом кала, а также наличием слизи (бродильная диспепсия).
- Протеи – могут вызывать запоры и острые кишечные инфекции с лихорадкой. При попадании в мочеполовые пути они могут стать причиной цистита, простатита и пиелонефрита.
Сальмонеллы
Грамотрицательные факультативно-анаэробные неспорообразующие бактерии представляют собой тонкие палочки длиной до 7 мкм и способны передвигаться с помощью жгутиков.
Эти микроорганизмы патогенны для человека. В норме сальмонеллы должны отсутствовать в анализе кала на дисбактериоз. Они могут вызывать серьезное заболевание — острое кишечное инфекционное заболевание, известное как сальмонеллез.
Заражение сальмонеллезом возможно как от больного человека, так и через употребление зараженного мяса, молока, птицы или яиц. Куриные яйца являются основным источником распространения сальмонелл, поэтому их термическая обработка крайне важна, особенно если блюдо предназначено для маленьких детей. Замораживание, засаливание и копчение мяса не уничтожают сальмонеллы. Для их истребления необходима длительная варка, тушение или запекание.
Шигеллы
Грамотрицательные факультативно-анаэробные неподвижные неспорообразующие бактерии представляют собой короткие палочки длиной до 3 мкм с закругленными концами. Шигеллы, близкие родственники сальмонелл, принадлежат к одному семейству и представляют опасность для здоровья человека.
В анализе кала на дисбактериоз рядом со шигеллами должен стоять знак минус, так как в норме эти микроорганизмы отсутствуют. Шигеллы являются возбудителями шигеллеза, более известного как дизентерия. Это острое кишечное заболевание сопровождается высокой температурой, болями в животе, тошнотой, рвотой и поносом.
Заражение дизентерией может происходить фекально-оральным или контактно-бытовым способом. Наиболее распространённые пути передачи — от больного человека, через загрязнённую воду, немытые руки, а также овощи и фрукты. Кроме того, распространению шигеллеза способствуют мухи и тараканы.
Иерсинии
Грамотрицательные факультативно-анаэробные палочковидные бактерии размером от 2 до 4 мкм представляют опасность для здоровья человека. При анализе кала на дисбактериоз в разделе «иерсинии» следует указывать прочерк или сокращение «neg».
Эти микроорганизмы являются возбудителями иерсиниоза — острого кишечного заболевания, проявляющегося лихорадкой, диспепсическими расстройствами, болями в животе и кожными высыпаниями.
Иерсинии обитают в почве. Основной путь заражения для человека — контакт с больными домашними животными, такими как хомячки, кролики, кошки, собаки и попугаи. Также заражение возможно через употребление пищи и воды, которые могли соприкасаться с этими питомцами. Кроме того, иерсиниоз может передаваться при уходе за сельскохозяйственными животными, такими как свиньи, коровы и куры.
Синегнойная палочка
Грамотрицательная облигатно-аэробная подвижная бактерия представлена короткими (до 5 мкм) прямыми или изогнутыми палочками с закруглёнными концами. Учёные не пришли к единому мнению о классификации синегнойной палочки: она может быть отнесена как к условно-патогенным, так и к патогенным микроорганизмам. При интерпретации результатов анализа кала на дисбактериоз желательно, чтобы эта бактерия не была обнаружена.
Синегнойная палочка может вызывать воспалительные процессы в желудочно-кишечном тракте, мочеполовой системе, дыхательных путях, а также в сердце и мягких тканях. Она является причиной 20% внутрибольничных инфекций, 25% гнойно-септических осложнений после операций и 35% всех случаев абсцессов и флегмон.
Заражение синегнойной палочкой чаще всего происходит от инфицированного человека через воздушно-капельный или контактно-бытовой путь. Также она может передаваться через заражённые продукты питания и загрязнённую воду.
Эшерихия гемолитическая
Гемолитическая или гемолизирующая эшерихия — патогенный штамм кишечной палочки, опасный для человека. Термин «гемолиз» обозначает разрушение красных кровяных клеток — эритроцитов. В норме в анализе кала на дисбактериоз должно быть указано, что гемолитической эшерихии у пациента не обнаружено.
Этот микроорганизм вызывает эшерихоз — острое заболевание, проявляющееся болями в животе, тошнотой, диареей, рвотой, повышением температуры, головной болью, головокружением, общей слабостью и обезвоживанием. Все эти симптомы являются следствием токсического воздействия гемолитической кишечной палочки.
Заражение происходит через загрязненные продукты питания и воду. Утешает, что для массового заболевания требуется попадание в желудочно-кишечный тракт значительного количества эшерихий. Болезнь протекает быстро (от 3 до 6 дней) и редко приводит к осложнениям. Однако для пожилых людей с ослабленным иммунитетом и маленьких детей гемолитическая кишечная палочка может представлять серьёзную опасность.
Стафилококк золотистый
Завершая нашу беседу о расшифровке результатов анализа кала на дисбактериоз, обратим внимание на одного из самых опасных представителей патогенной кишечной флоры — золотистый стафилококк. Хотя его правильнее классифицировать как условно-патогенную бактерию, около 25% населения Земли являются бессимптомными носителями этого микроорганизма. Это означает, что золотистый стафилококк может находиться под контролем иммунной системы. Некоторые специалисты допускают наличие этого микроба в образце кала в концентрации 10³ КОЕ/г, в то время как другие считают нормой исключительно отрицательный результат.
Большинство людей сталкиваются с «незваным гостем» еще в детстве, когда происходит внутрибольничное распространение золотистого стафилококка или заражение в детских садах. Первое попадание значительного количества возбудителя в организм может вызвать яркие симптомы кишечной инфекции всего через 4-5 часов: тошноту, рвоту, боли в животе, понос с примесью слизи и крови, обезвоживание, высокую температуру, слабость, отсутствие аппетита, головокружение и иногда гипотонию. Лечение этого заболевания представляет собой серьезную задачу, так как золотистый стафилококк обладает высокой устойчивостью к антибиотикам. Обычно терапия включает восстановление микрофлоры кишечника и, при необходимости, стимуляцию иммунной системы. Чтобы избежать подобных проблем, крайне важно соблюдать правила личной гигиены, особенно в общественных местах, и приучать к этому детей. Заботьтесь о своем здоровье и будьте внимательны к своему самочувствию!
Вопрос-ответ
Какие показатели в анализе кала указывают на дисбактериоз?
Что показывает анализ кала на дисбактериоз? В анализе оценивается концентрация и соотношение «полезных» (лактобактерии, бифидобактерии, кишечная палочка), условно-патогенных (энтеробактерии, стафилококки, клостридии, грибы) и патогенных (шигеллы, сальмонеллы) микроорганизмов.
Как читать отчет об анализе кала?
Если надосадочная жидкость приобретает зеленовато-коричневый оттенок, это свидетельствует о наличии восстанавливающего вещества (тест положительный). Если количество восстанавливающего вещества в кале < 0, 25 мг/дл, результат теста нормальный. Если оно составляет 0, 25–0, 5 мг/дл, результат теста подозрительный. Если оно > 0, 5 мг/дл, результат теста аномальный.
Советы
СОВЕТ №1
Перед сдачей анализа кала на дисбактериоз, проконсультируйтесь с врачом о необходимости временного прекращения приема антибиотиков и пробиотиков, так как они могут повлиять на результаты исследования.
СОВЕТ №2
Соблюдайте правила сбора образца: используйте чистую и сухую емкость, избегайте загрязнения кала мочой или другими веществами, чтобы получить наиболее точные результаты.
СОВЕТ №3
Обратите внимание на сроки доставки образца в лабораторию. Чем быстрее анализ будет проведен после сбора, тем более достоверными будут результаты, так как микрофлора может изменяться со временем.
СОВЕТ №4
После получения результатов анализа, не спешите делать выводы самостоятельно. Обсудите их с врачом, который сможет правильно интерпретировать данные и предложить необходимые рекомендации по лечению или коррекции рациона.